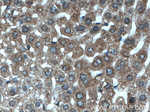
POFUT2 Antibody in Immunohistochemistry (Paraffin) (IHC (P))

Search
Proteintech
POFUT2 Polyclonal Antibody
{{$productOrderCtrl.translations['antibody.pdp.commerceCard.promotion.promotions']}}
{{$productOrderCtrl.translations['antibody.pdp.commerceCard.promotion.viewpromo']}}
{{$productOrderCtrl.translations['antibody.pdp.commerceCard.promotion.promocode']}}: {{promo.promoCode}} {{promo.promoTitle}} {{promo.promoDescription}}. {{$productOrderCtrl.translations['antibody.pdp.commerceCard.promotion.learnmore']}}
产品信息
17764-1-AP
种属反应
已发表种属
宿主/亚型
分类
类型
抗原
偶联物
形式
浓度
规格
纯化类型
保存液
内含物
保存条件
运输条件
产品详细信息
Immunogen sequence: ASGQEFWPG QSAADILSGA ASRRRYLLYD VNPPEGFNLR RDVYIRIASL LKTLLKTEEW VLVLPPWGRL YHWQSPDIHQ VRIPWSEFFD LPSLNKNIPV IEYEQFIAES GGPFIDQVYV LQSYAEGWKE GTWEEKVDER PCIDQLLYSQ DKHEYYRGWF WGYEETRGLN VSCLSVQGSA SIVAPLLLRN TSARSVMLDR AENLLHDHYG GKEYWDTRRS MVFARHLREV GDEFRSRHLN STDDADRIPF QEDWMKMKVK LGSALGGPYL GVHLRRKDFI WGHRQDVPSL EGAVRKIRSL MKTHRLDKVF VATDAVRKEY EELKKLLPEM VRFEPTWEEL ELYKDGGVAI IDQWICAHAR FFIGTSVSTF SFRIHEEREI LGLDPKTTYN RFCGDQEKAC EQPTHWKITY (21-429 aa encoded by BC064623)
靶标信息
Fucose is typically found as a terminal modification of branched chain glycoconjugates, but it also exists in direct O-linkage to serine or threonine residues within cystine knot motifs in epidermal growth factor-like repeats or thrombospondin type-1 repeats. POFUT2 is an O-fucosyltransferase that use THBS type-1 repeats as substrates.
仅用于科研。不用于诊断过程。未经明确授权不得转售。
生物信息学
蛋白别名: GDP-fucose protein O-fucosyltransferase 2; O-FucT-2; Peptide-O-fucosyltransferase 2; unnamed protein product
基因别名: 2310011G23Rik; AI256847; BC003494; C21orf80; FUT13; KIAA0958; POFUT2
UniProt ID: (Human) Q9Y2G5, (Mouse) Q8VHI3
Entrez Gene ID: (Human) 23275, (Rat) 309686, (Mouse) 80294